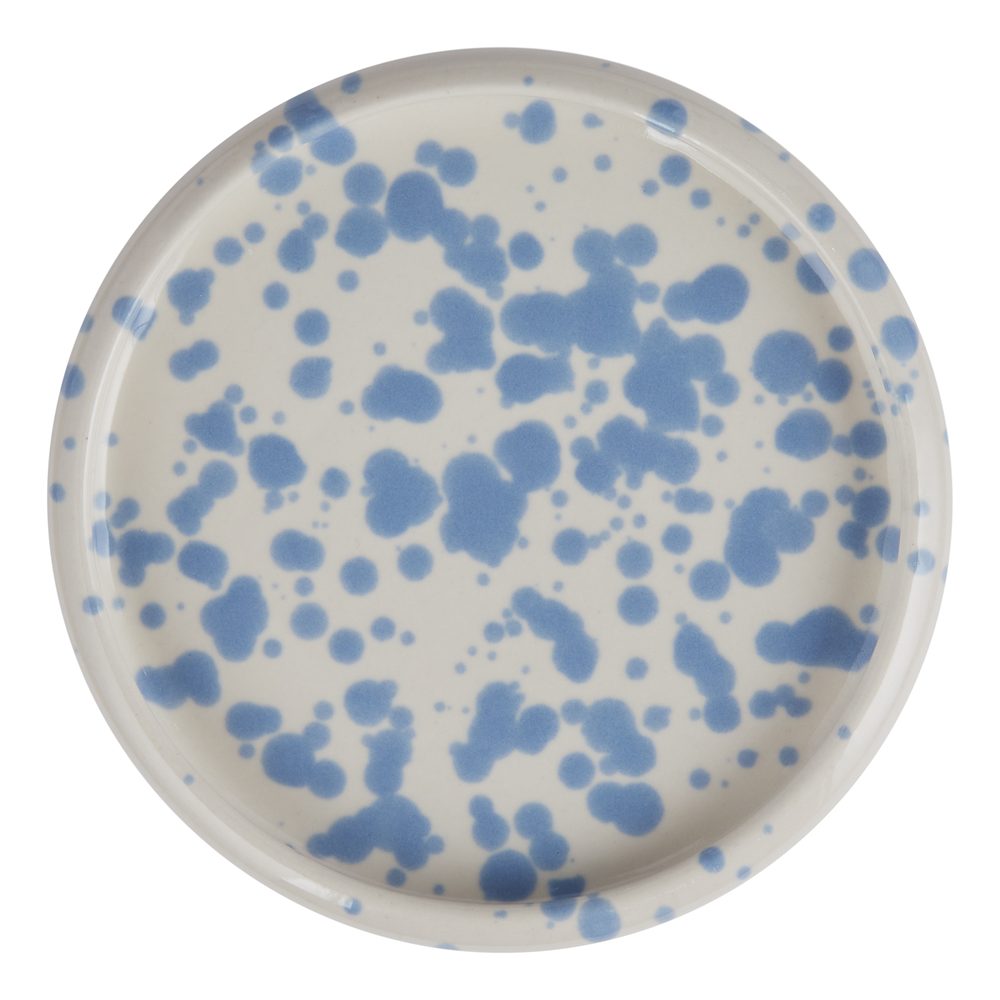

O prodejci Butlers.cz
Butlers je e-shop specializující se na prodej nábytku a dekorací do bytu, který kombinuje funkčnost s moderním designem. Nabízí široký sortiment produktů, od sofistikovaných kusů nábytku, jako jsou stoly, židle a skříně, po drobné bytové doplňky,…
Benefity prodejce Butlers.cz
- ✭ Doprava nad 2 500 Kč ZDARMA (nevztahuje se na nábytek)
- ✭ Speciální nabídka k narozeninám (při odběru newsletteru)
- ✭ 30 dní na vrácení zboží
- ✭ Zboží ve slevě na Butlers.cz
- ✭ Novinky na Butlers.cz
- ✭ Zkušenosti a recenze s Butlers.cz
BOOGY SPLASH Talíř 12 cm - sv. modrá
Materiál: kamenina Rozměry: Výška: 2 cm, Ø 12 cm Lze mýt v myčce. Na nádobí Boogy Splash tančí živé tečky. Minimalistický, vysoce kvalitní kameninový servis s organickými tvary a moderními oblouky připomínajícími frisbee dodá vašemu stolu opravdu jedinečný vzhled. Díky čisté barevné škále a charakteristickému designu jsou talíře a misky Boogy Splash opravdovými statement kousky na stole. Jsou k dispozici v několika barvách, takže si můžete snadno sestavit vlastní Mix & Match kombinaci.
Cena: 149 Kč
| Dostupnost | Skladem |
|---|---|
| Prodejce | Butlers.cz |
| Výrobce | BOOGY SPLASH (23 produktů) |
| ID produktu | 000000001000503767 |
| EAN | 4035644734826 |
| Heureka Kategorie | Stolování | Talíře |
| Distribuce | CZ |
Vybrané produkty
Charakter Ment Nádobí Talíř TalířeMožnosti dopravy a ceny
| Způsob dopravy | Cena |
| Zásilkovna | 59 Kč |
|---|---|
| Zásilkovna na dobírku | 108 Kč |
| DPD | 99 Kč |
| DPD na dobírku | 148 Kč |
| Zásilkovna na adresu | 99 Kč |
| Zásilkovna na adresu s dobírkou | 148 Kč |